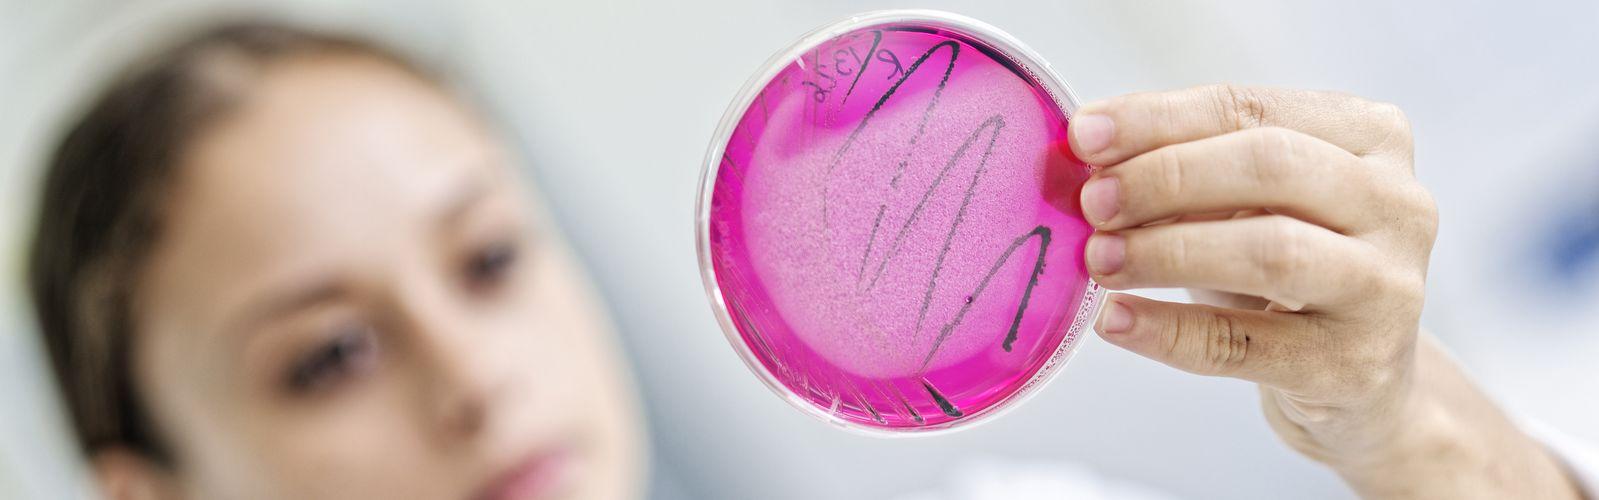

Joint Research Unit (UMR) - ES Department
- Home
- About us
- Research units
Research units
29 Results
Joint Research Unit (UMR) - PERSYST Department
Biodiversified Agrosystems - UMR ABSys
Internal Research Unit (UPR) - PERSYST Department
Agroecology and Sustainable Intensification for Annual Crops - UPR AIDA
Joint Research Unit (UMR) - BIOS Department
Genetic Improvement and Adaptation of Mediterranean and Tropical Plants - UMR AGAP
Service Unit (US) - PERSYST Department
Water, Soil and Plant Analysis - US Analyses
Internal Research Unit (UPR) - BIOS Department